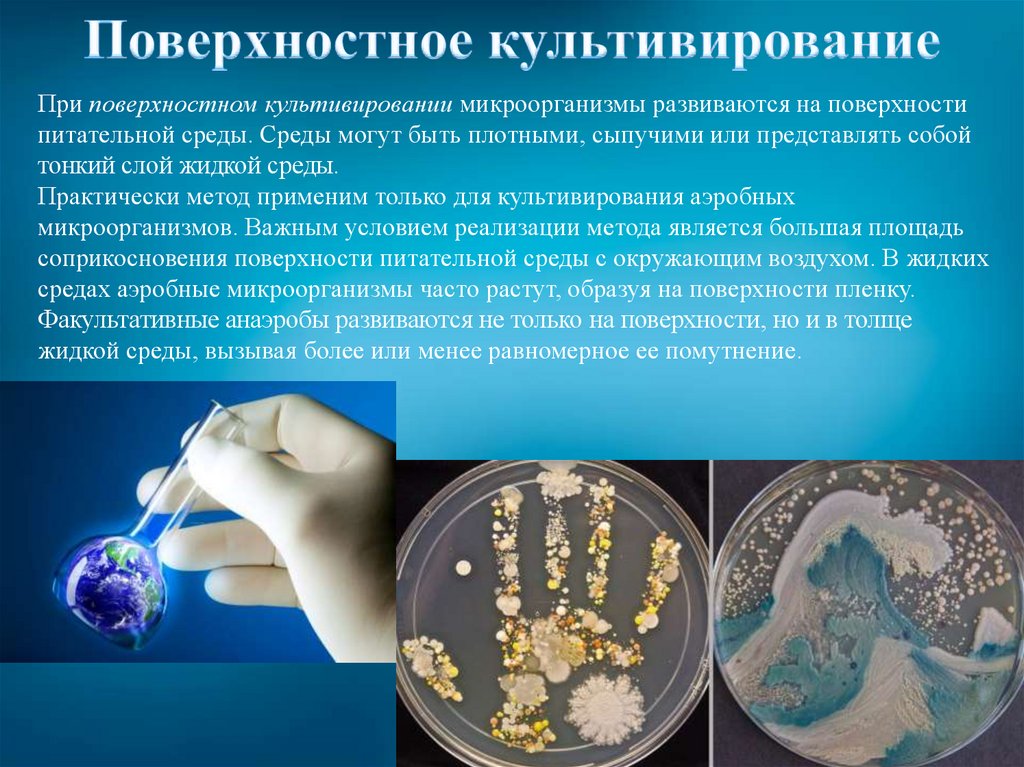
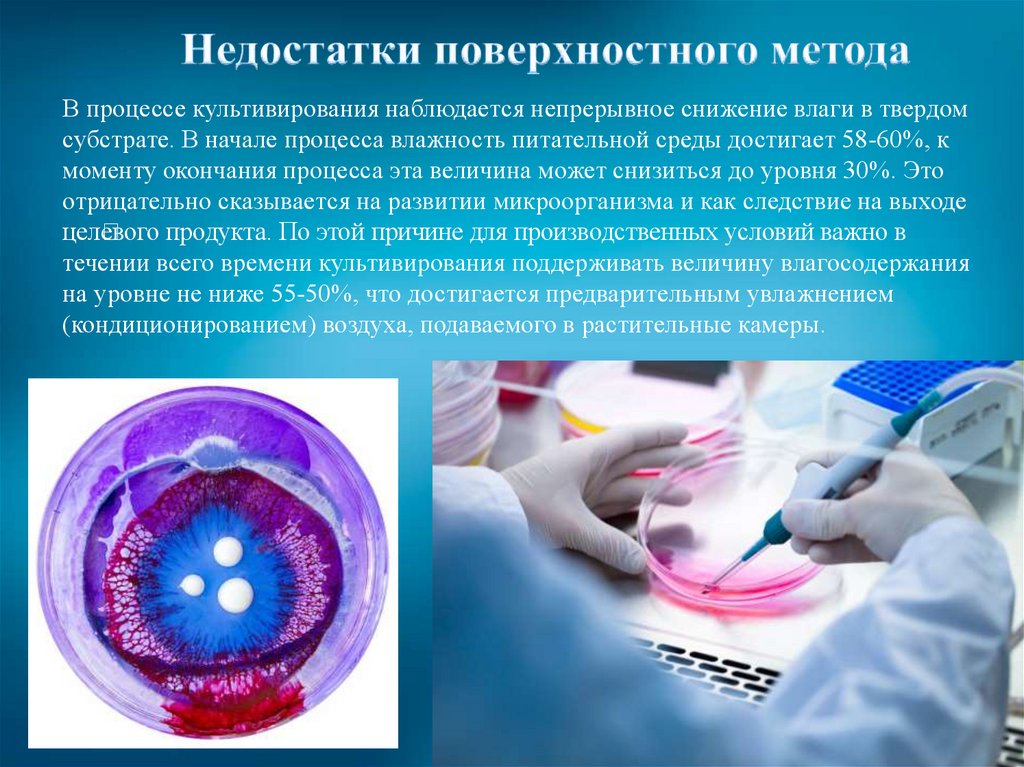
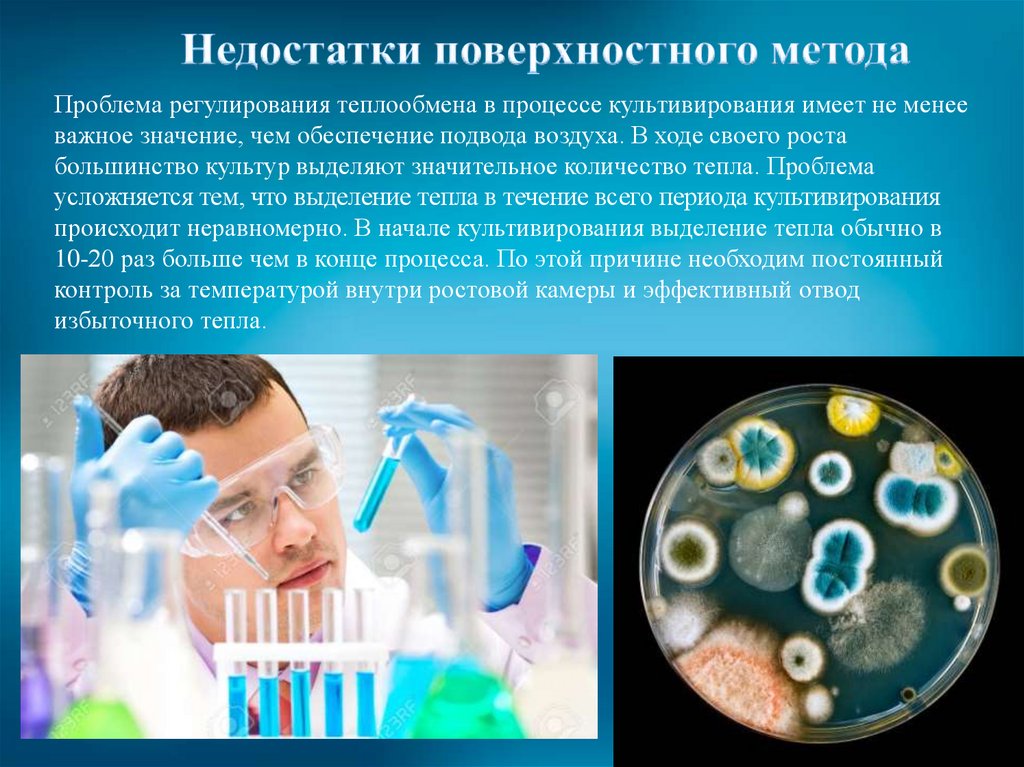

Похожие презентации:
Методы культивирования микроорганизмов. Часть 1
1.
ЛекцияМетоды культивирования
микроорганизмов
Часть 1
2.
План лекции• Методы культивирования микроорганизмов
Факторы, влияющие на рост микроорганизмов
- источники азота,
- источники углерода,
- макро- и микроэлементы,
- ростовые факторы,
- доноры и акцепторы водорода
3.
1Поверхностное
2
Глубинное
3
Периодическое
4
Непрерывное
При использовании экстенсивных методов культивирование вида на питательной
среде является прерывистым, т. е. организм через определенное время
пересевается на новую среду.
Интенсивные методы культивирования характеризуются непрерывностью при
постоянном или периодическом отборе продукции и внесении какого-то количества
питательных веществ.
4.
При поверхностном культивировании микроорганизмы развиваются на поверхностипитательной среды. Среды могут быть плотными, сыпучими или представлять собой
тонкий слой жидкой среды.
Практически метод применим только для культивирования аэробных
микроорганизмов. Важным условием реализации метода является большая площадь
соприкосновения поверхности питательной среды с окружающим воздухом. В жидких
средах аэробные микроорганизмы часто растут, образуя на поверхности пленку.
Факультативные анаэробы развиваются не только на поверхности, но и в толще
жидкой среды, вызывая более или менее равномерное ее помутнение.
5.
— выделение чистых культур из объектов внешней среды;— определение контаминации производственных штаммов
микроорганизмов, из которых готовят биопрепараты;
— приготовление в лабораторных и промышленных
условиях некоторых вакцин и большинства антигенов
6.
Вначале пенициллин получали методом поверхностного культивирования. Технологиябыла весьма примитивна — продуцент культивировали в колбах или бутылках. Для
культивирования продуцента использовали даже молочные бутылки, так как имелись
машины для их мытья и обработки. В каждую бутылку помещали питательную среду
слоем толщиной 1—4 см, что обеспечивало необходимые условия аэрации. Бутылки
помещали в специальные корзины, стерилизовали, а затем охлаждали. Сухие споры
или их водную суспензию вносили в бутылки особыми пульверизаторами или при
помощи пипеток и ферментировали 5—10 сут при температуре 24°С.
7.
Поверхностный способ выращивания микроскопических грибов имеет рядпреимуществ. Так как во время роста гриба отруби не перемешиваются,
посторонние микроорганизмы не распространяются по всей их массе и
вызывают лишь незначительное местное инфицирование, которое, как
правило, не влияет на активность ферментов. Это, однако, не исключает
необходимости тщательной стерилизации воздуха, среды и оборудования.
8.
Недостаток поверхностного способа – необходимость устанавливать множествокювет, работу с которыми трудно механизировать. Себестоимость культуры
гриба-продуцента высока, причем в основном из-за затраты большого количества
ручного труда.
9.
В процессе культивирования наблюдается непрерывное снижение влаги в твердомсубстрате. В начале процесса влажность питательной среды достигает 58-60%, к
моменту окончания процесса эта величина может снизиться до уровня 30%. Это
отрицательно сказывается на развитии микроорганизма и как следствие на выходе
цел
евого продукта. По этой причине для производственных условий важно в
течении всего времени культивирования поддерживать величину влагосодержания
на уровне не ниже 55-50%, что достигается предварительным увлажнением
(кондиционированием) воздуха, подаваемого в растительные камеры.
10.
Проблема регулирования теплообмена в процессе культивирования имеет не менееважное значение, чем обеспечение подвода воздуха. В ходе своего роста
большинство культур выделяют значительное количество тепла. Проблема
усложняется тем, что выделение тепла в течение всего периода культивирования
происходит неравномерно. В начале культивирования выделение тепла обычно в
10-20 раз больше чем в конце процесса. По этой причине необходим постоянный
контроль за температурой внутри ростовой камеры и эффективный отвод
избыточного тепла.

Биология
Биология








